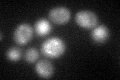
YFL026W
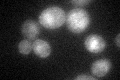
YFL026W

View description
Receptor for alpha-factor pheromone; seven transmembrane-domain GPCR that interacts with both pheromone and a heterotrimeric G protein to initiate the signaling response that leads to mating between haploid a and alpha cells
Localization:
Intensity:
Fold change:
Significance:
-
C’ GFP library in SD

vacuole, cell periphery69.37 -
N' NOP1pr-GFP in SD

ambiguous44.2186 -
N' TEF2pr-mCherry in SD

below threshold0 -
N' NATIVEpr-GFP in SD

missing0 -
N' TEF2pr-VC and Cyto-VN in SD

#N/A0 -
C’ GFP library in SD+DTT
vacuole, cell periphery21.640.31Yes -
C’ GFP library in SD+H2O2
vacuole, cell periphery34.540.49Yes -
C’ GFP library in Starvation Media

vacuole, cell periphery21.390.3Yes -
C’ GFP library on the background of Pup2-DaMP

vacuole -
C’ GFP library on the background of CCT mutant

vacuole, cell periphery53.10270.765421No
